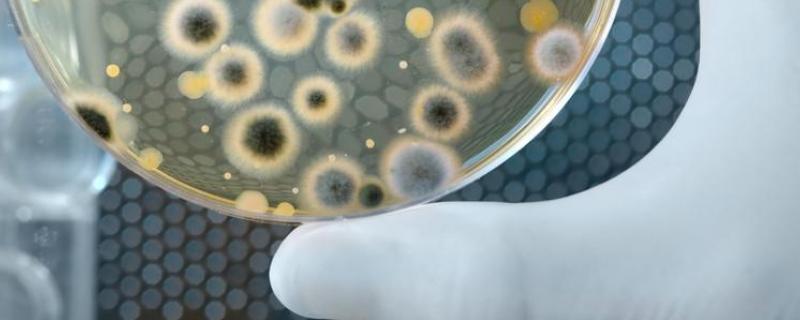

要问菌种名词解释菌种扩大培养名词解释,据悉在发酵过程中,能作为活细胞催化剂的微生物就叫做菌种,菌种主要来源于自然界的微生物,在经过人工处理后,便可从这些微生物筛选分离出有用菌种,从而用于生产中。其中筛选的步骤包括了菌种分离、初筛和复筛,其主要的目的在于从微生物中,选出具有某种能力的有用菌种。
一、菌种名词解释
1、菌种是指在发酵过程中,能作为活细胞催化剂的微生物,主要包括了细菌、放线菌、酵母菌以及霉菌四个种类,菌种主要来源于自然界的微生物,然后通过人工处理的方法,从这些微生物中筛选分离后选出有用菌种,加以改良,便可以将这些菌种用于生产中。
2、筛选主要是为了选出对工业发酵有用的菌种,其步骤主要包括了菌种分离、初筛和复筛,从中选出具有某种能力的有用菌种。
3、分离首先需要从土壤或者腐生植物中收集含菌样品,接着将样品用无菌水稀释后,再将其涂在适宜细菌、放线菌或者霉菌生长的琼脂培养基平皿上,然后再将它倒置于恒温箱中。经过一段时间的培养后,平皿上会长出的许多单个菌落,菌落经过分离后就可变成各种纯种菌株。不使用时可将它移种至试管斜面培养基上,放在温度为4℃的冰箱中备用。
二、菌种扩大培养名词解释
1、菌种扩大培养指对保藏菌种进行活化以及逐级繁殖培养,从而为发酵生产提供相当数量且代谢旺盛并满足一定生理要求的微生物细胞(种子)的方法。
2、菌种扩大培养的过程为首先将保藏菌种进行琼脂斜面活化,接着将其放入摇瓶(液体)或者茄形培养瓶(固体)中繁殖培养,然后将其转入种子罐进行扩大培养。
3、种子的罐级数可根据种子罐和发酵罐容积以及接种量的具体需要来确定,通常分为1级或者2级,但有时候也需要3级,比如在链霉素生产中,就需要采用3级种子罐进行菌种的扩大培养。





















